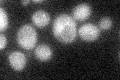
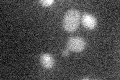

View description
Protein required for nuclear retention of unspliced pre-mRNAs along with Mlp1p and Pml1p; anchored to nuclear pore complex via Mlp1p and Mlp2p; found with the subset of nuclear pores farthest from the nucleolus; may interact with ribosomes
Localization:
Intensity:
Fold change:
Significance:
-
C’ GFP library in SD
below threshold18.5 -
N' NOP1pr-GFP in SD

punctate,nucleus36.769 -
N' TEF2pr-mCherry in SD

punctate,nucleus13.5187 -
N' NATIVEpr-GFP in SD

punctate,nuclear periphery26.7415 -
N' TEF2pr-VC and Cyto-VN in SD

below threshold21.065 -
C’ GFP library in SD+DTT

cytosol16.680.9No -
C’ GFP library in SD+H2O2

cytosol17.590.95No -
C’ GFP library in Starvation Media
cytosol22.621.22No -
C’ GFP library on the background of Pup2-DaMP

below threshold -
C’ GFP library on the background of CCT mutant

below threshold17.51140.945939No
